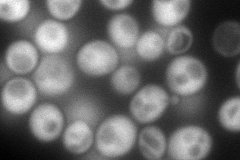
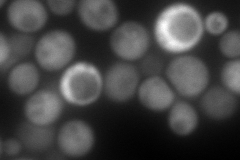
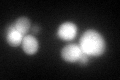

View description
UDP-N-acetylglucosamine pyrophosphorylase, catalyzes the formation of UDP-N-acetylglucosamine (UDP-GlcNAc), which is important in cell wall biosynthesis, protein N-glycosylation, and GPI anchor biosynthesis
Localization:
Intensity:
Fold change:
Significance:
-
C’ GFP library in SD

cytosol41.45 -
N' NOP1pr-GFP in SD
cytosol212.815 -
N' TEF2pr-mCherry in SD
cytosol289.543 -
N' NATIVEpr-GFP in SD

ambiguous29.4394 -
N' TEF2pr-VC and Cyto-VN in SD

#N/A0 -
C’ GFP library in SD+DTT
cytosol58.11.4Yes -
C’ GFP library in SD+H2O2

cytosol47.681.15No -
C’ GFP library in Starvation Media

cytosol34.790.83No -
C’ GFP library on the background of Pup2-DaMP

cytosol -
C’ GFP library on the background of CCT mutant

cytosol42.4841.02493No
